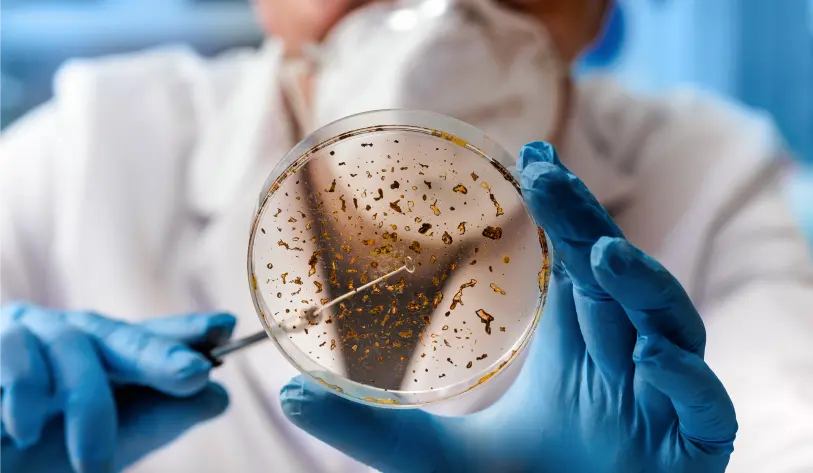

UPDATE - Tivano Cutting Boards Are Having a LIMITED TIME Warehouse Clearance Sale! Save 50% OFF!
This cutting board is transforming kitchens worldwide—and traditional board manufacturers HATE IT.
Limited Time Sale: 50% OFF Tivano TitaniumShield™ Cutting Boards

Meet Sarah, a health-conscious mom of two. She thought she was doing everything right—organic food, clean cooking, regular kitchen sanitizing. But one day, her youngest son got violently sick after dinner.
"I couldn’t figure out why," Sarah recalls. "Then I saw the deep scratches on my plastic cutting board—the ones I could never fully clean. My heart dropped."

Most people assume their cutting board is safe. But research reveals a terrifying reality:
🔴 Plastic Boards shed microplastics into your food—linked to cancer, infertility, and organ damage.
🔴 Wooden Boards absorb bacteria like Salmonella and E. coli—increasing food poisoning risk by 200%.
🔴 Glass Boards destroy knives and leave invisible glass shards in meals.
Dr. Robert Langley, a leading microbiologist, warns:"Your cutting board is a breeding ground for deadly pathogens. Scratches trap bacteria, wood absorbs toxins, and plastic leaches chemicals. Every meal becomes a contamination risk."
Desperate for a solution, Sarah discovered Tivano—the world’s first self-sanitizing cutting board with TitaniumShield™ Technology.

✅ Bacteria-Proof Surface – Nano-coating repels 99.9% of germs, mold, and odors.
✅ Zero Microplastics – No BPA, PFAS, or toxic chemicals.
✅ Scratch-Proof & Knife-Friendly – Stays smooth for years, keeps blades razor-sharp.
✅ Dishwasher-Safe – Cleans in seconds—no scrubbing or staining.

Week 1:
Week 2:
Week 3:
Week 4:
Dr. Langley confirms:"Tivano’s TitaniumShield™ is a game-changer. Unlike wood or plastic, it doesn’t harbor bacteria or leach toxins. It’s the only cutting board I recommend."

The transformation begins the moment you switch to Tivano TitaniumShield™. From the very first use, its advanced bacteria-proof surface starts protecting your food—eliminating hidden germs and preventing contamination.
This is why users immediately notice:
✅ No lingering odors from garlic, onions, or fish.
✅ No more knife-dulling grooves that ruin blades.
✅ Effortless cleaning—just wipe or toss in the dishwasher.
The TitaniumShield™ nano-coating repels bacteria, mold, and stains from the very first chop. Unlike wood or plastic, it doesn’t absorb juices or trap microbes—keeping your food 100% safe.
"I used to worry about raw meat contamination. With Tivano, I prep without fear." – Verified Customer
While traditional boards degrade over time, Tivano stays flawless. Its scratch-proof surface means:
✔ No bacteria-hiding grooves
✔ No warping or staining
✔ No microplastic shedding
"After a week, my old plastic board looked disgusting. Tivano still looks brand new!" – Home Chef Review
This is where Tivano truly shines. Users report:
🔹 Knives stay sharper longer (saving $$$ on sharpening)
🔹 Zero maintenance—no oiling, sanding, or scrubbing
🔹 Peace of mind knowing every meal is prepared safely
"I’ve had mine for 6 months—still perfect. My entire kitchen is safer because of Tivano." – Professional Chef

A consumer study of 2,500+ households revealed:
"This isn’t just a cutting board—it’s a kitchen essential that eliminates risks you didn’t even know existed." – Dr. Robert Langley, Microbiologist






EDITOR'S NOTE: Time-Sensitive Opportunity
Due to the advanced manufacturing process required for the TitaniumShield™ nano-coating, Tivano can only produce a limited number of cutting boards each month.
The last batch sold out in just 48 hours during our previous sale, leaving thousands of home chefs on a waiting list.
But today, we've secured an exclusive allocation for our readers!

For the next 24 hours only, you can claim your Tivano TitaniumShield™ Cutting Board at an unprecedented 50% discount.
Each purchase comes with our "Zero Risk, 100% Satisfaction" guarantee – if you're not completely amazed by the difference Tivano makes in your kitchen within 30 days, we'll refund every penny.
Don't let another meal be prepared on a dangerous, bacteria-ridden cutting board. Every day you wait is another day your family is exposed to:
1️⃣ 50% OFF + Fast Shipping
2️⃣ 30-Day Money-Back Promise
3️⃣ Lifetime Durability – Never replace your board again
Your kitchen deserves this upgrade. Your family's health is worth it. Click the button below to secure your Tivano before this offer expires!
⭐⭐⭐⭐⭐ "I threw out all my old cutting boards after trying Tivano. The difference is night and day!" – Sarah K., Verified BuyerORDER NOW
I've been looking for a safer cutting board option! Has anyone actually used this Tivano board?
Okay, I was totally skeptical at first, but WOW! My food prep is so much cleaner now and I swear my knives stay sharper. This board has become my kitchen essential!
I've been using my Tivano board daily for weeks, and I'm amazed how easy it is to keep clean. No more scrubbing stains or worrying about bacteria. Total game-changer for my cooking routine!
Didn't think a cutting board could make much difference, but this one actually does. My food prep feels safer, and I love that it doesn't absorb odors like my old wooden board did.
This cutting board has completely transformed my kitchen experience! No more cross-contamination worries, no more ruined knives, and cleanup takes seconds. Why didn't I switch sooner?
The Tivano board is seriously impressive! After just a few uses I noticed my knives weren't dulling as fast, and the non-porous surface gives me peace of mind about food safety. Highly recommend!
Robert Jenkins, Texas
"It's not just a cutting board - it's a kitchen revolution! Truly groundbreaking technology. I hope big kitchenware companies don't try to copy this... Definitely worth every penny - the results speak for themselves! My wife loves her Tivano board too!"
TRY NOW